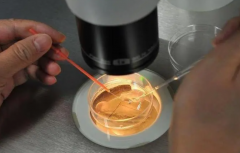
试管自然周期移植：回归自然，三大优势与潜在挑战

助孕指南

-
 人工授精VS试管:辅助生殖手段大比拼
人工授精VS试管:辅助生殖手段大比拼辅助生殖人授与试管都是帮助不孕不育夫妇实现生育愿望的技术,但它们之间存在3点区别。第一,精子和卵子的结合方式不同;第二,适应症不同;第三,费用不同。具体选择哪种技术,需要根
作者:木易 109 发布时间:2026-04-14 -
 长方案OR短方案?试管前的关键抉择,一文读懂
长方案OR短方案?试管前的关键抉择,一文读懂试管长方案和短方案各有优缺点,没有绝对的好坏之分。长方案能够更好地控制排卵时间,提高胚胎质量,但需要较长时间的治疗和较高的激素水平。短方案则适用于年龄较大或卵巢功能较差
作者:木易 94 发布时间:2026-04-14 -
 降调后第二月非必移?揭秘移植时机的黄金法则
降调后第二月非必移?揭秘移植时机的黄金法则打了降调第二个月是否需要移植,并不一定要根据个人意愿或者固定模式来决定,而是要以身体条件为关键。如果身体条件允许,那么可以在第二个月进行移植,但如果身体条件不满足,则不
作者:婷婷 180 发布时间:2026-04-14 -
 揭秘试管移植降调14天全流程,助您好孕一臂之力!
揭秘试管移植降调14天全流程,助您好孕一臂之力!试管移植降调14天的用药流程包括使用促排卵药物、降调药物等。这些药物的作用是促进卵泡发育、调节内分泌,提高试管成功率。降调14天后,医生会根据患者的激素水平、卵泡大小等因素来
作者:婷婷 74 发布时间:2026-04-14 -
 试管卵泡质量提升秘籍:四大技巧助你圆梦
试管卵泡质量提升秘籍:四大技巧助你圆梦要提高试管卵泡质量,可以尝试以下四个技巧,其中第一个技巧效果明显。首先,保持健康的生活方式。均衡饮食、适度运动和充足休息是关键。增加摄入富含蛋白质、维生素和矿物质的
作者:婷婷 72 发布时间:2026-04-14 -
 试管一代长方案全面解析:优劣势对比
试管一代长方案全面解析:优劣势对比试管一代长方案是试管治疗中常用的一种方案,其优点在于可以促进多卵泡发育和同步排卵,从而提高妊娠率和试管成功率。但是,长方案也存在一些缺点,如治疗周期长、药物剂量
作者:婷婷 54 发布时间:2026-04-14 -
 掌握试管养囊秘籍,降低风险从了解原理到流程
掌握试管养囊秘籍,降低风险从了解原理到流程在进行试管治疗时,养囊是重要的一步,但同时也存在一定的风险。养囊是将胚胎在实验室中培养一段时间,以增加其发育潜力,但同时也增加了胚胎染色体异常的风险。因此,在选择是
作者:wednesday 175 发布时间:2026-04-14 -
 试管超长方案成功率揭秘:高达50%的秘密武器!
试管超长方案成功率揭秘:高达50%的秘密武器!试管过程中,采用超长方案促排的经验有以下四点,被证实非常有效。首先,合理安排治疗时间。根据个人情况和医生建议,选择合适的治疗时间,以确保卵巢处于最佳状态,增加卵泡的
作者:婷婷 153 发布时间:2026-04-14 -
 输卵管阻塞并非只能做试管怀孕:深度解析其他治疗方法
输卵管阻塞并非只能做试管怀孕:深度解析其他治疗方法输卵管阻塞并不一定意味着只能通过试管来怀孕。除了试管,还有其他治疗方法可以帮助输卵管阻塞的患者实现怀孕。例如,可以通过手术、药物或者辅助生殖技术等方法来治疗输卵
作者:婷婷 111 发布时间:2026-04-14 -
 试管降调后卵泡发育不良?三步补救调理秘籍大公开!
试管降调后卵泡发育不良?三步补救调理秘籍大公开!试管降调后卵泡偏小,可以采取多吃豆类食物;豆类食物中含有丰富的植物雌激素,能促进卵泡发育。或者多吃高蛋白食物;高蛋白食物能为卵泡提供营养,促进其发育。如果饮食调理效果不佳,
作者:婷婷 193 发布时间:2026-04-14 -
 身体正常夫妻可以做试管吗?前提是这4个条件得满足!
身体正常夫妻可以做试管吗?前提是这4个条件得满足!身体正常的夫妻 能否做试管,需要符合这些前提条件:男女双方必须结婚,有合法的生育证明;女方的卵巢能够正常产生卵子;男女双方的生殖系统必须正常,没有传染性疾病和遗传性疾病
作者:婷婷 130 发布时间:2026-04-14 -
试管自然周期移植:回归自然,三大优势与潜在挑战
试管自然周期移植:回归自然,三大优势与潜在挑战试管自然周期移植的优点包括:无需进行促排卵治疗,减少了对卵巢的刺激;可以避免药物对身体的副作用;能够更好地模拟自然受孕的过程,提高胚胎着床的成功率。但是,这种移植方式也存在
作者:婷婷 60 发布时间:2026-04-14
